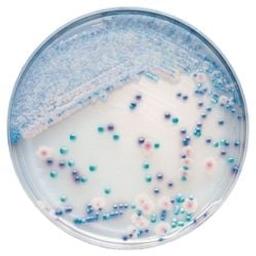
BD BBL™ CHROMagar™ Candida Plate

BD BBL™ CHROMagar™ Candida Plate
BD BBL™ CHROMagar™ Candida medium is a selective and differential medium for presumptively identifying members of the genus Candida from a primary isolation plate. Due to the differences in morphology and colors of the yeast colonies, this medium is particularly useful in the detection of mixed yeast cultures in specimens. Colonies of C. albicans appear light to medium green, C. tropicalis colonies appear light blue to metall…

The supplier does not provide quotations for this product through SelectScience. You can search for similar products in our Product Directory.
The BBL™ CHROMagar™ family of products utilize a chromogen mix that consists of artificial substrates (chromogens) that release differently colored compounds upon degradation by specific microbial enzymes, thus assuring the direct differentiation of certain species or the detection of certain groups of organisms with only a minimum of confirmatory tests.
BD BBL™ CHROMagar™ Candida
• Unrivaled accuracy for the isolation and direct identification of Candida albicans, C. tropicalis and C. krusei (which may be fluconazole-resistant) without the need for additional confirmation tests.
• Isolation and identification within 20 hours.**
• Differentiates mixed yeast isolates usually not differentiated on other fungal isolation media from clinical specimens.
• Inhibits normal bacterial flora (using chloramphenicol) making it an ideal medium for primary yeast culture of urine, genital, and throat samples.
** Note that an incubation of 42 hours is required for the full-color development of the colonies.
Note: Not all products are available in all geographies, please contact your local BD representative for product details, specs, or ordering information.